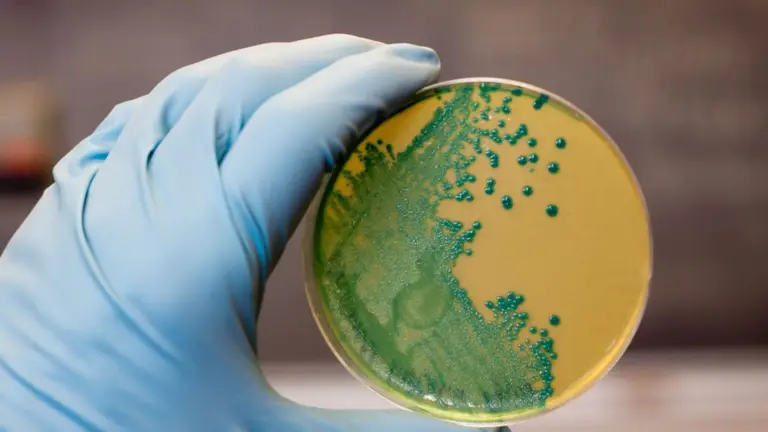

NOTAS RELACIONADAS
Las autoridades de Estados Unidos emitieron una advertencia tras el retiro del mercado de varios lotes del producto Gambas al ajillo con linguini de la marca Scott & Jon’s. La medida, anunciada por la Administración de Alimentos y Medicamentos (FDA), se debe a la posible presencia de la bacteria Listeria monocytogenes, que puede causar graves problemas de salud si se consume el producto contaminado.
El retiro fue ordenado por Demers Food Group, fabricante del producto, luego de detectarse que uno de los ingredientes —la pasta linguini— provenía del proveedor Nate’s Fine Foods, quien previamente había retirado su producto del mercado por contaminación. Los tazones fueron distribuidos en todo el país entre el 15 y el 25 de septiembre, afectando tanto a mayoristas como a operadores de alimentos.
Detalles del producto afectado
Los consumidores pueden identificar los productos potencialmente contaminados con la siguiente información:
-
Nombre del producto: Gambas al ajillo con linguini de Scott & Jon’s
-
Tamaño: 9,6 onzas
-
Códigos de lote: S254522, S255522, S259522, S263521 y S263522
-
Fechas de consumo preferente: 12/3/2027, 13/3/2027, 17/3/2027 y 21/3/2027
-
UPC: 858175003919 / GTIN: 10858175003916
Recomendaciones de la FDA a los consumidores
Hasta el momento no se han reportado casos de enfermedades vinculadas al consumo de este producto. Sin embargo, la FDA recomienda no ingerirlo bajo ninguna circunstancia, los consumidores deben desecharlo o devolverlo al punto de compra para obtener un reembolso.
Además, se aconseja limpiar y desinfectar las superficies que hayan estado en contacto con el alimento, ya que la Listeria puede sobrevivir en refrigeradores y utensilios.
Síntomas y riesgos de la infección por Listeria
La infección por Listeria monocytogenes puede causar síntomas como fiebre alta, dolores musculares, rigidez, náuseas, dolor abdominal y diarrea. Los grupos más vulnerables incluyen a mujeres embarazadas, adultos mayores, niños pequeños y personas inmunodeprimidas, quienes pueden sufrir complicaciones graves, como abortos espontáneos o infecciones sistémicas severas.